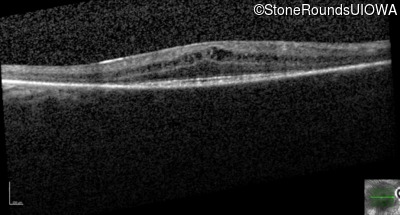
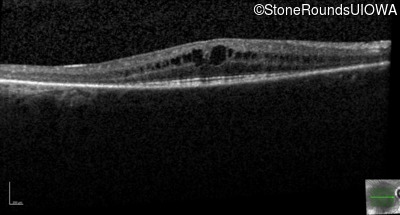
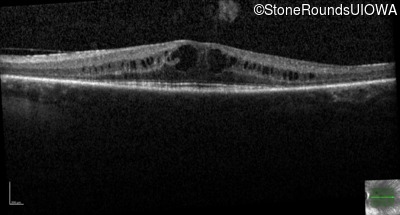
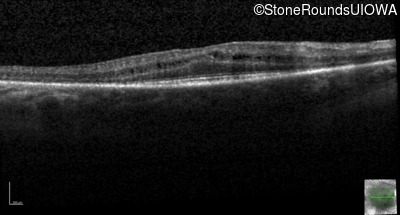
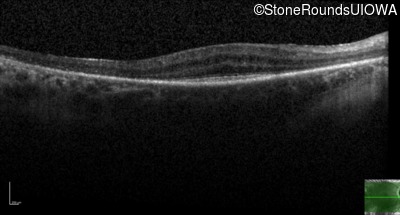
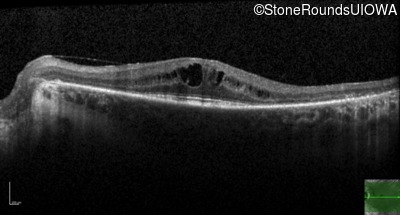
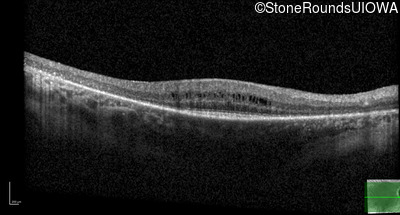
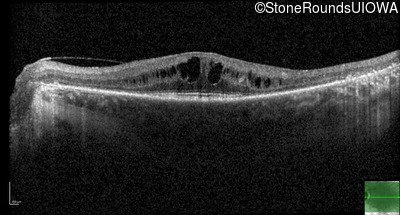
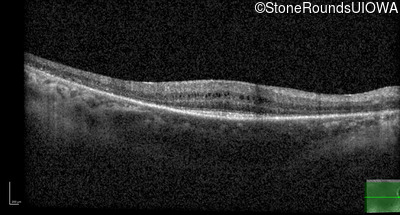
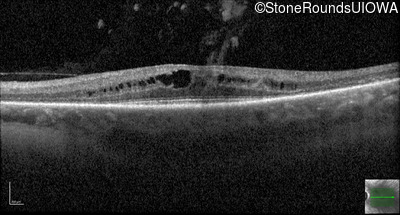
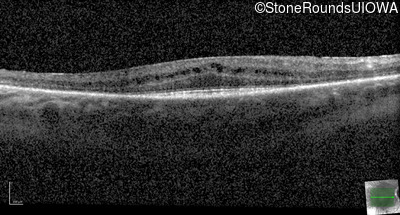
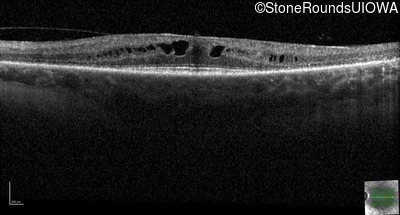

Case
SR717
Student Mode
AD Retinitis Pigmentosa (IA1aii)
Male
Male
Hidden
SR717
Student Mode
AD Retinitis Pigmentosa (IA1aii)
Male
Male
History
This 49 year old man first noticed some difficulties seeing in dim light in junior high school. Fundus abnormalities were first seen at age 20. His parents were both examined in our clinic and neither had any fundus abnormalities.
| Age at visit: 41 years |
| OD | OS | ||
|---|---|---|---|
| Age at visit: 49 years (Visit 2) |
| Age at visit: 53 years |
Diagnosis & molecular findings
| Disease | Gene | Allele 1 variant(s) | Allele 2 variant(s) | Inheritance mode |
|---|---|---|---|---|
| AD Retinitis Pigmentosa | PRPF31 | Lys73Stop AAG>TAG | AD |